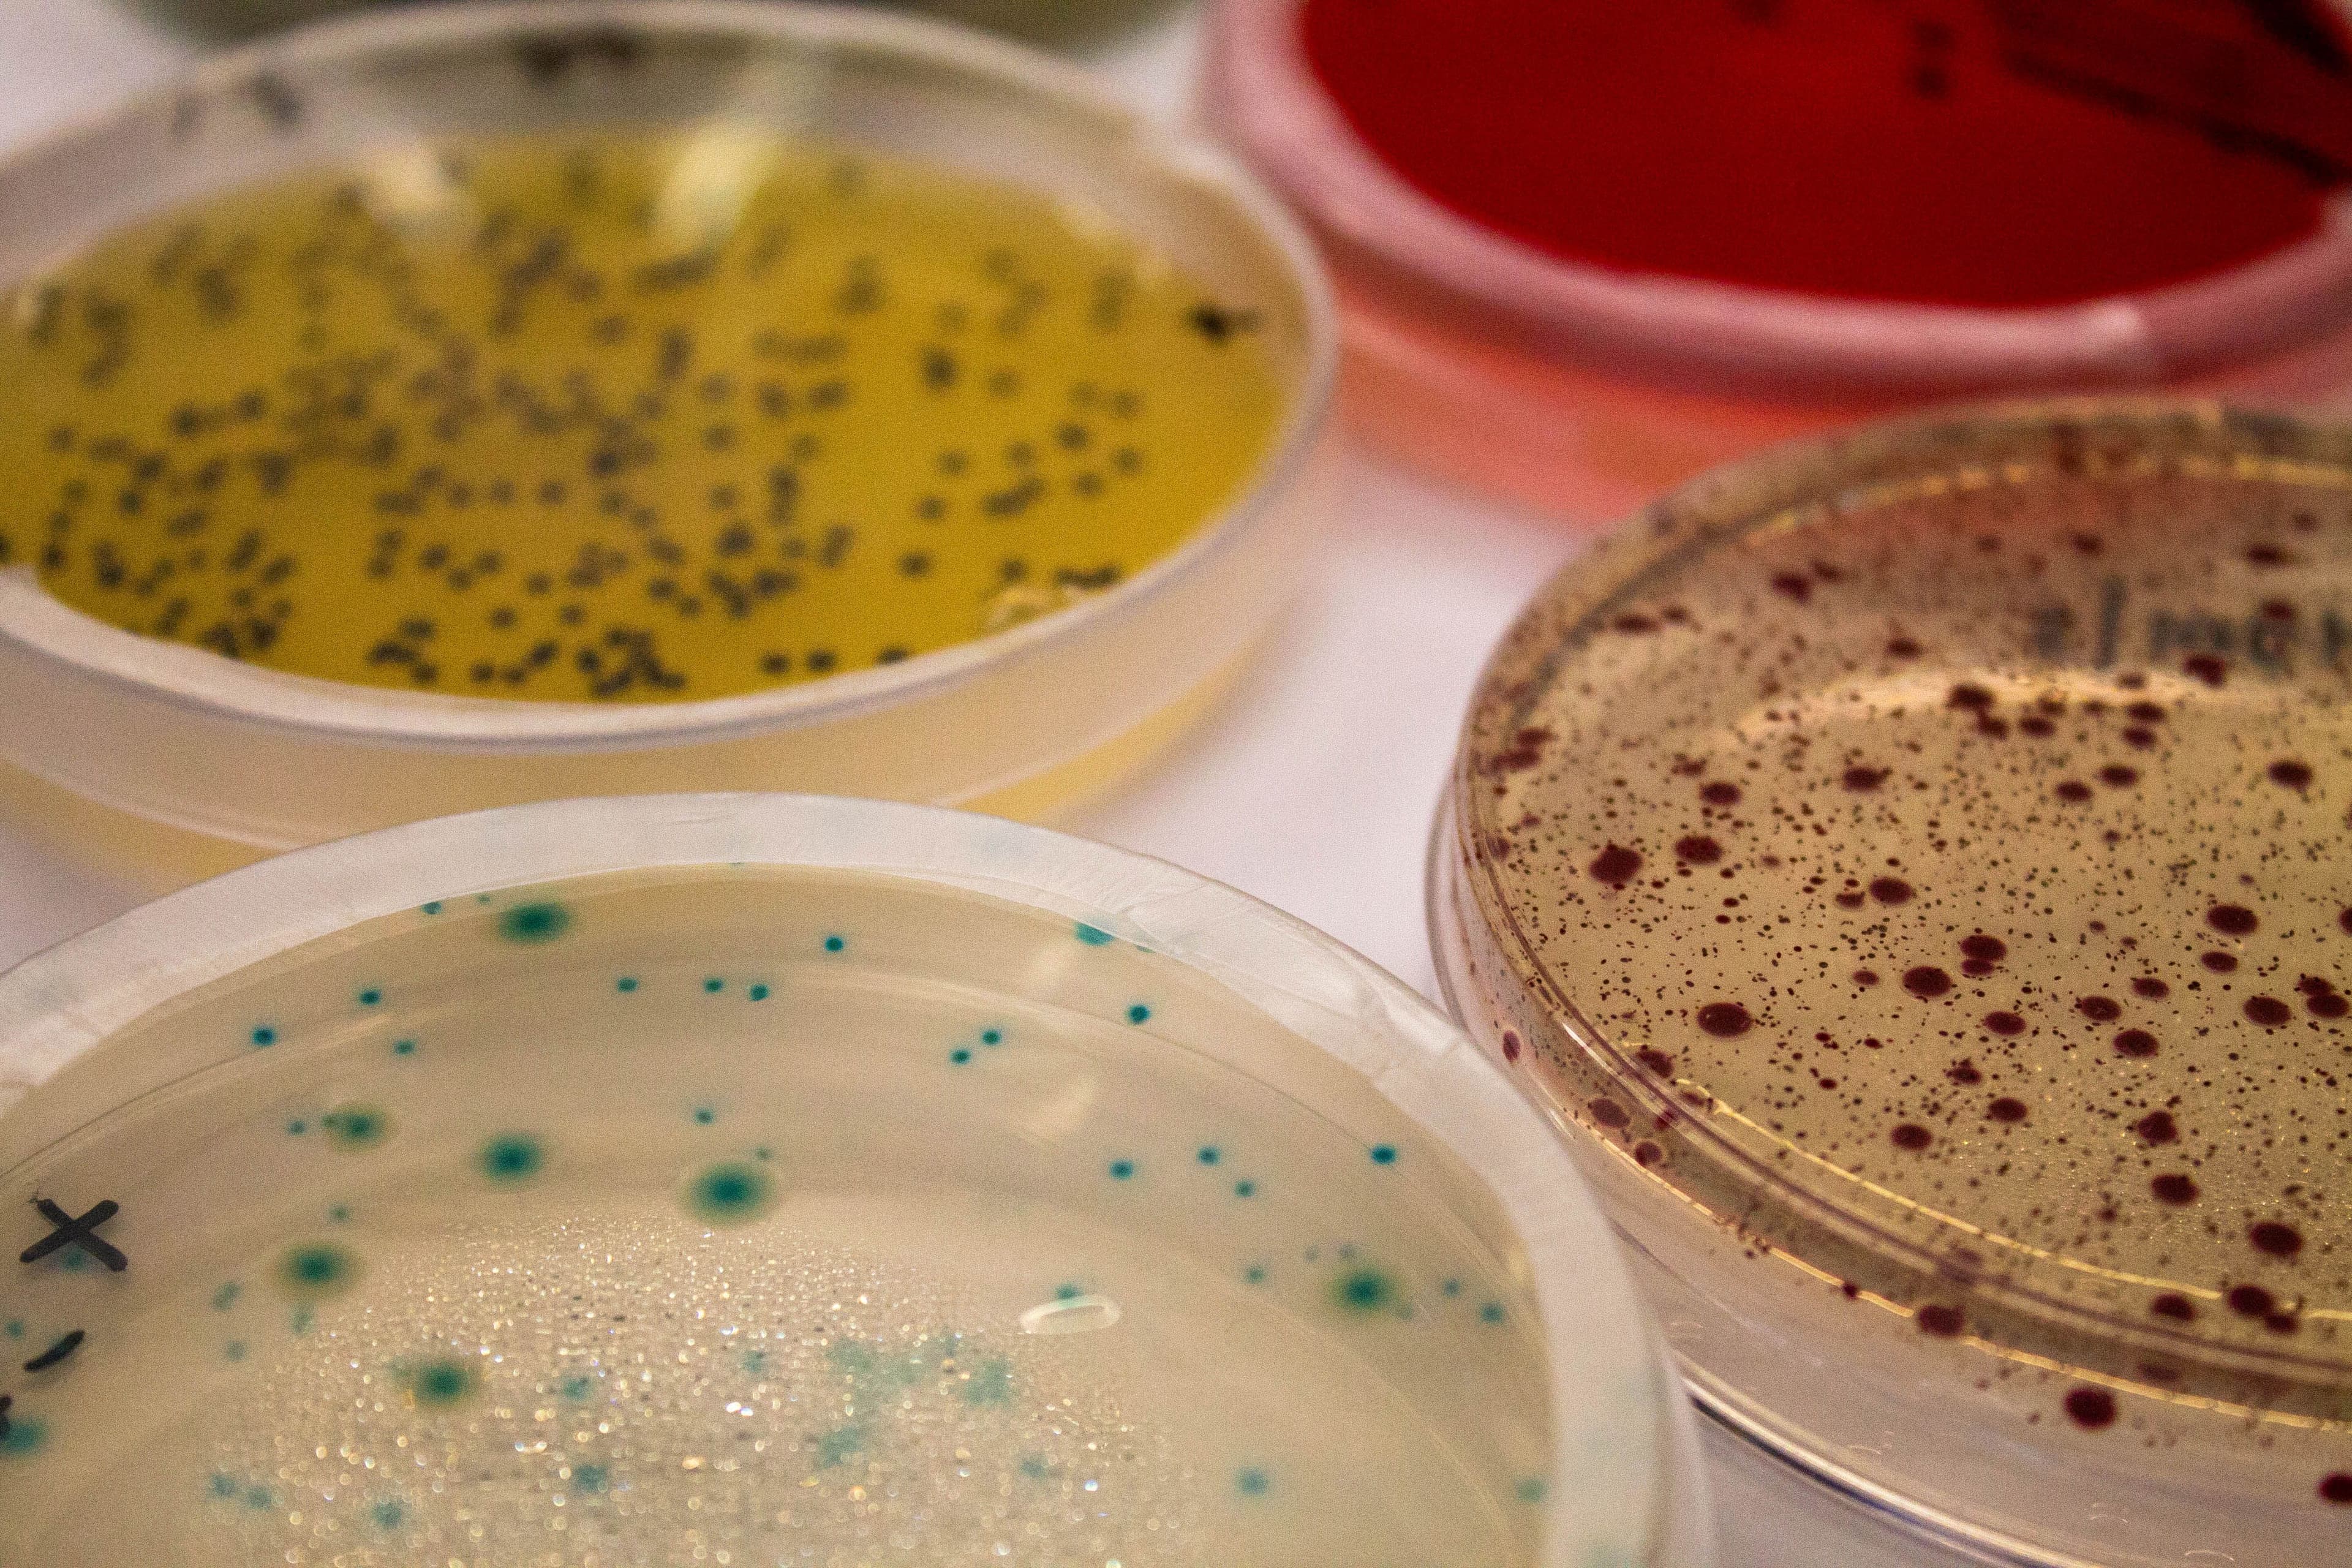
Laboratorios

Biotecnología Ambiental

Biotecnología Ambiental
SOLUCIONES BIOTECNOLÓGICAS PARA GESTIÓN AMBIENTAL Y TRATAMIENTO DE RESIDUOS
La Unidad de Biotecnología Ambiental desarrolla servicios especializados basados en procesos biológicos para apoyar la gestión ambiental, el tratamiento de residuos y efluentes y la mitigación de impactos en distintos sectores productivos.
Su trabajo se orienta a la aplicación de biotecnología para la remediación ambiental, el tratamiento de aguas y residuos, y la optimización de procesos con foco en la sustentabilidad, eficiencia y reducción de impactos ambientales, aportando soluciones técnicas para una gestión ambiental más responsable.
VALOR TÉCNICO
- Laboratorio Microbiología y Biotecnología Ambiental (Facultad Ingeniería UC)
- Laboratorio de Corrosión Marina y Biofouling (Estación Costera de Investigaciones Marinas, Facultad de Ciencias Biológicas UC)
- Laboratorio de Microbiología Marina (Facultad de Ciencias Biológicas UC)







